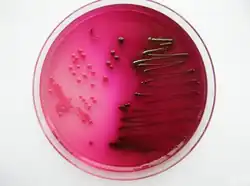

Gélose Endo

La gélose Endo est un milieu de culture sélectif et différentiel employé en microbiologie pour l'isolement et l'identification des bacilles Gram négatifs. Ce milieu comporte un indicateur coloré qui détecte la consommation du lactose. Il a été décrit pour la première fois en 1904 par S. Endo afin d'améliorer les performances de la gélose Drigalski dans la distinction entre Escherichia coli et le « bacille typhique » responsable de la typhoïde[1] (on sait à présent qu'il s'agit du sérotype Typhi de Salmonella enterica subsp. enterica).
Principe
La base nutritive se compose simplement de peptone peptique de viande et de lactose à parts égales.
Le milieu est doté d'un système indicateur original à base de fuchsine basique décolorée par réduction avec du sulfite de sodium. Comme l'explique l'auteur dans sa publication originale, la fuchsine basique est un mélange principalement constitué de chlorhydrate de rosaniline : c'est cette substance qui est décolorée par le sulfite de sodium et qui se recolore en rouge sous l'effet des sous-produits acides sécrétés par les bactéries capables de métaboliser le lactose[1]. Comme le sulfite de sodium est partiellement détruit par oxydation lors du chauffage et de l'autoclavage du milieu, sa quantité doit être ajustée en excès par rapport à la quantité de fuchsine pour que le milieu reste incolore ou au moins très pâle après autoclavage[2],[3].
La fuchsine basique et le sulfite de sodium jouent aussi le rôle d'inhibiteurs pour limiter la croissance des bactéries Gram positives[4]. L'hydrogénophosphate de potassium joue le rôle de tampon. L'agar est l'agent gélifiant.
Lecture
L'aspect des colonies sur gélose Endo reflète leur aptitude à acidifier le lactose.
Les colonies qui acidifient le lactose (colonies « lactose + » en abrégé) sont colorées en rouge sombre avec un éclat métallique à doré. Les autres (colonies « lactose – ») sont d'aspect incolore ou translucide[5].
Composition
Pour 1 000 mL de milieu[5] :
- peptone peptique de viande : 10 g
- lactose : 10 g
- hydrogénophosphate de potassium : 3,5 g
- sulfite de sodium : 2,5 g
- fuchsine basique : 500 mg
- agar : 15 g
Ajuster le pH à 7,4 ± 0,2 à 25 °C (après autoclavage).
Variantes
Selon les fournisseurs et les formulations[5] :
- la quantité de fuchsine basique peut être abaissée à 400 mg/L[6] ou même 300 mg/L[7] ;
- la quantité d'agar peut être abaissée à 12,5 g/L[7] ou même 10 g/L ;
- le pH peut être ajusté à 7,5 ± 0,2 à 25°C[5],[6].
La gélose m-Endo LES est un milieu dérivé conçu pour le dénombrement sur membrane filtrante des bactéries coliformes dans les eaux.
Préparation
Aucun ingrédient n'étant thermosensible, il suffit de les dissoudre à chaud dans le volume correspondant d'eau distillée et de stériliser à l'autoclave (15 min à 121 °C). Le mélange est ensuite réparti dans des contenants stériles.
Notes et références
- 1 2 Endo S « Ueber ein Verfahren zum Nachweis der Typhubacillen » Centralbl Bakteriol 1 Orig. 1904;35(1):109-110. Accès libre (article en allemand).
- ↑ Ruata GQ « Das Verfahren von Endo zur Differenzierung des Bacillus von Eberth vom Colibacillus » Centralbl Bakteriol 1 Orig. 1904;36(4):576-584. Accès libre (article en allemand).
- ↑ De même, les milieux préparés doivent être conservés à l'abri de la lumière avant usage pour limiter les réactions indésirables de photo-oxydation susceptibles de recolorer la fuchsine.
- ↑ Corry JEL et al.. Handbook of culture media for food and water microbiology. Cambridge, UK : 3rd edition, 2011, RSC Publishing, p. 458. (ISBN 978-1-84755-916-6) DOI 10.1039/9781847551450.
- 1 2 3 4 « Endo Agar » in: Atlas RM & Snyder JW. Handbook of media for clinical and public health microbiology. Boca Raton : 2014, CRC Press, Taylor & Francis Group, p. 181. (ISBN 978-1-4665-8293-4).
- 1 2 « Endo Agar Base » in: Atlas RM & Snyder JW. Handbook of media for clinical and public health microbiology. Boca Raton : 2014, CRC Press, Taylor & Francis Group, p. 181. (ISBN 978-1-4665-8293-4).
- 1 2 « Endo Agar, Modified » in: Atlas RM & Snyder JW. Handbook of media for clinical and public health microbiology. Boca Raton : 2014, CRC Press, Taylor & Francis Group, p. 182. (ISBN 978-1-4665-8293-4).
Voir aussi
- Portail de la microbiologie